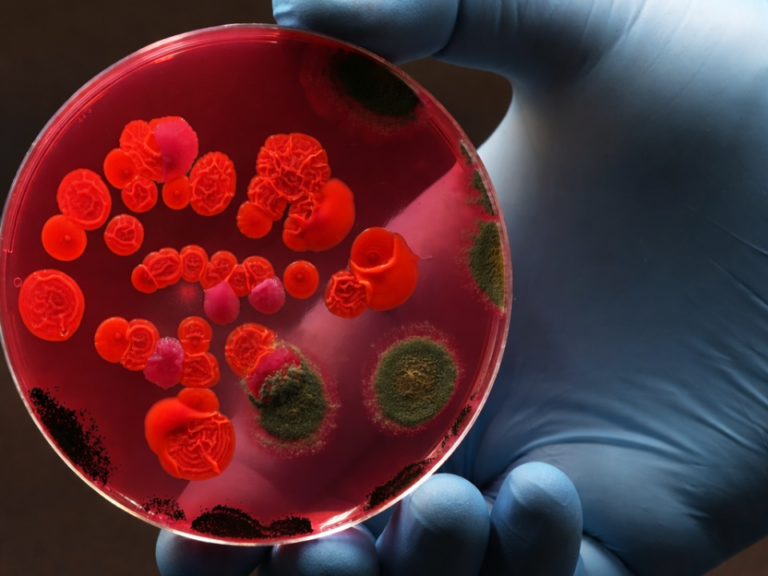
Análise microbiana em placa de Petri com diferentes colônias cultivadas em meio sólido, ilustrando métodos clássicos aplicados à ciência analítica e microbiologia.

Avanços em análise microbiana estão transformando a forma como grandes volumes de dados genômicos são organizados, interpretados e aplicados em estudos preditivos de doenças. Essas inovações representam um salto metodológico na ciência analítica, ao integrar bioinformática, estatística avançada e automação computacional para compreender sistemas biológicos altamente complexos.
Historicamente, a caracterização microbiana baseava-se em um conjunto restrito de marcadores genéticos e abordagens comparativas limitadas. Esse modelo, embora funcional, mostrava-se insuficiente diante do crescimento exponencial dos bancos de dados genômicos e da diversidade microbiana observada em ambientes clínicos, industriais e ambientais.
Seleção dinâmica de marcadores genéticos e filogenia automatizada
Um dos principais avanços recentes em análise microbiana está na automatização da construção de árvores filogenéticas, com seleção dinâmica de marcadores genéticos a partir de grandes conjuntos de genomas. Diferentemente dos métodos tradicionais, que utilizam sempre os mesmos genes de referência, essa abordagem identifica, de forma computacional, os marcadores mais informativos para cada grupo microbiano analisado.
Do ponto de vista analítico, isso resulta em modelos filogenéticos mais robustos, capazes de representar com maior fidelidade as relações evolutivas entre micro-organismos, inclusive quando os genomas estão incompletos ou fragmentados. Para laboratórios que trabalham com vigilância microbiológica, controle de qualidade ou P&D, esse ganho metodológico reduz vieses interpretativos e aumenta a confiabilidade das análises comparativas.
Infraestrutura computacional como ferramenta analítica
Outro ponto fundamental desses avanços é o fortalecimento de plataformas computacionais abertas, projetadas para manipulação, comparação e integração de dados microbiológicos em larga escala. Essas bibliotecas de software oferecem recursos que vão desde análise de diversidade microbiana até preparação de dados para aplicações em aprendizado de máquina.
Na prática, a análise microbiana passa a ser tratada como um processo analítico completo, no qual a qualidade dos dados, a escolha dos algoritmos e a rastreabilidade das etapas analíticas são tão relevantes quanto em qualquer método instrumental clássico. Essa convergência aproxima a bioinformática dos princípios da química analítica moderna, com foco em reprodutibilidade, validação e interpretação crítica dos resultados.
Impactos na predição de doenças e em aplicações industriais
A incorporação dessas estratégias avançadas de análise microbiana amplia significativamente a capacidade de predição de doenças, ao permitir a identificação precoce de padrões microbianos associados a estados patológicos ou alterações ambientais. Em vez de análises pontuais, os modelos passam a considerar comunidades microbianas como sistemas dinâmicos, sensíveis a pequenas variações detectáveis apenas por métodos analíticos sofisticados.
Além do contexto clínico, essas ferramentas têm impacto direto em áreas como indústria farmacêutica, biotecnologia, alimentos e meio ambiente, onde o monitoramento microbiológico é crítico para segurança, desempenho de processos e conformidade regulatória.
Uma nova fronteira para a ciência analítica
Os avanços em análise microbiana reforçam uma tendência clara, a expansão do escopo da ciência analítica para além dos métodos instrumentais tradicionais. A integração entre dados genômicos, bioinformática e modelagem preditiva posiciona o analista como um profissional estratégico, capaz de interpretar sistemas complexos e apoiar decisões baseadas em evidência quantitativa.
Nesse cenário, a análise microbiana passa a ocupar um papel central na geração de conhecimento preditivo, consolidando-se como uma das fronteiras mais promissoras da ciência analítica contemporânea.